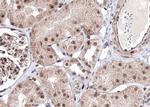
Phospho-AMPK beta-1 (Ser181) Antibody in Immunohistochemistry (Paraffin) (IHC (P))
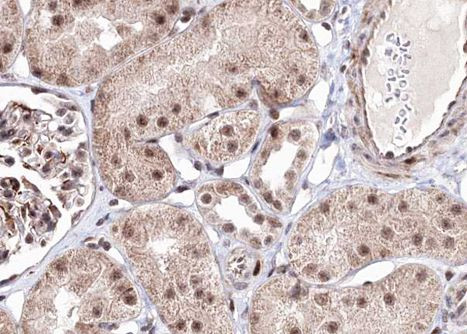
Phospho-AMPK beta-1 (Ser181) Antibody in Immunohistochemistry (Paraffin) (IHC (P))

Search
Invitrogen
Phospho-AMPK beta-1 (Ser181) Polyclonal Antibody
{{$productOrderCtrl.translations['antibody.pdp.commerceCard.promotion.promotions']}}
{{$productOrderCtrl.translations['antibody.pdp.commerceCard.promotion.viewpromo']}}
{{$productOrderCtrl.translations['antibody.pdp.commerceCard.promotion.promocode']}}: {{promo.promoCode}} {{promo.promoTitle}} {{promo.promoDescription}}. {{$productOrderCtrl.translations['antibody.pdp.commerceCard.promotion.learnmore']}}
图: 1 / 3
Phospho-AMPK beta-1 (Ser181) Antibody (PA5-105044) in IHC (P)

产品信息
PA5-105044
宿主/亚型
分类
类型
抗原
偶联物
形式
浓度
保存条件
运输条件
RRID
产品详细信息
Antibody detects endogenous levels of AMPK beta 1 only when phosphorylated at Serine 181.
靶标信息
AMPK beta 1 is a regulatory subunit of the AMP-activated protein kinase (AMPK). AMPK is a heterotrimer consisting of an alpha catalytic subunit, and non-catalytic beta and gamma subunits. AMPK is an important energy-sensing enzyme that monitors cellular energy status. In response to cellular metabolic stresses, AMPK is activated, and thus phosphorylates and inactivates acetyl-CoA carboxylase (ACC) and beta-hydroxy beta-methylglutaryl-CoA reductase (HMGCR), key enzymes involved in regulating de novo biosynthesis of fatty acid and cholesterol. This subunit may be a positive regulator of AMPK activity. The myristoylation and phosphorylation of this subunit have been shown to affect the enzyme activity and cellular localization of AMPK. This subunit may also serve as an adaptor molecule mediating the association of the AMPK complex.
仅用于科研。不用于诊断过程。未经明确授权不得转售。